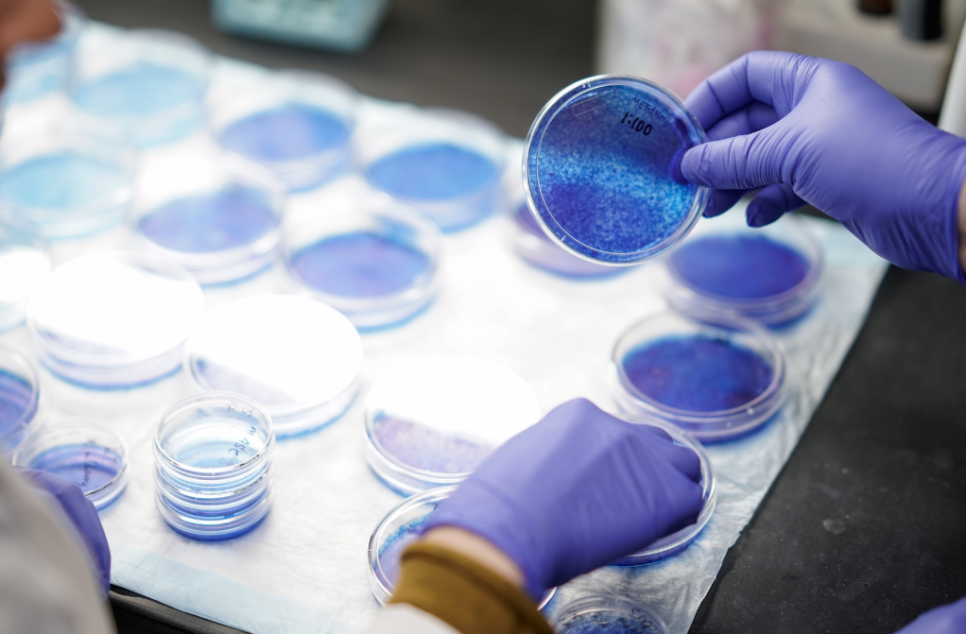

스웨덴이 췌장암 치료·연구의 최전선에 선 이유
– 새로운 면역치료, 세포치료 임상 중심으로 –
췌장암은 오랫동안 치료가 어려운 암종으로 알려져 있습니다. 생존율이 낮고 기존 치료법으로 큰 개선이 어려웠기 때문에, 면역치료·세포치료 기술을 접목한 연구가 전 세계적으로 활발합니다.
그 중 스웨덴 출신 바이오기업과 연구자들이 이 분야를 적극 이끌고 있어 의료계에서도 주목받고 있습니다.
스웨덴 기업이 주도하는 세포 기반 면역치료 임상
1) Anocca AB
- 스웨덴의 면역종양학 기업 Anocca는 KRAS 변이 표적으로 하는 TCR-T 세포치료제의 임상시험을 진행하고 있습니다.
- KRAS 변이는 췌장암 환자의 약 90% 이상에서 나타나 치료가 특히 어렵다고 알려진 주요 표적입니다.
이 기업은 특히 유럽에서 비바이러스(non-viral) 방식 유전자 편집 TCR-T 치료제를 활용하는 임상 프로그램을 시작했으며, 스웨덴을 포함한 유럽 주요 대학병원에서 Phase I 임상시험을 진행 중입니다.
📌 의미:
기존 화학요법이나 표적치료만으로는 효과가 제한적이었던 췌장암에 대해
환자 맞춤형 면역세포 치료 접근을 모색하는 중요한 시도입니다.
면역단백질 치료제 연구도 지속
2) Alligator Bioscience
Alligator Bioscience는 스웨덴 룬드 기반 바이오텍으로,
면역치료제 mitazalimab을 개발하고 있으며 췌장암 분야에서 중요한 임상 데이터를 발표하거나 공개할 예정입니다.
이 약물은 CD40 작용제로, 암 주변 면역환경을 활성화해 면역반응을 일으키는 종류의 치료제입니다.
이 회사는 2026년 미국 ASCO GI 학회에서 관련 임상 결과를 발표할 예정인데, 이를 통해 미래 치료 방향이 더욱 구체화될 전망입니다.
📌 의미:
단독 면역요법이 아닌, 기존 화학요법과 병용해 면역 반응을 촉진하는 복합형 치료 연구로 발전 방향이 확장되고 있어 중요한 전환점으로 꼽힙니다.

왜 스웨덴 연구가 주목받나?
✔ 비바이러스 TCR-T 세포치료가 유럽 최초로 임상 단계에 진입
Anocca의 ‘VIDAR-1’ 임상은
KRAS 같은 난치성 표적을 겨냥해 유럽에서 처음으로 비바이러스 기반 세포치료제 임상시험에 돌입했습니다.
이 기술은 기존 CAR-T 치료와는 달리, 보다 유연하고 다양한 종양 항원을 표적할 수 있어 앞으로 췌장암은 물론 다른 고형암 분야에서도 응용 가능성이 제기되고 있습니다.
췌장암 치료 연구의 글로벌 흐름 속 스웨덴
전 세계적으로는 KRAS 변이 및 면역미세환경을 공략하는 다양한 접근법이 연구되고 있는데, 스웨덴의 사례는 그 중심에 선 대표적인 예시입니다.
즉,
✔ 전통적 화학요법이 아닌
✔ 면역 강화 및 세포치료 기반의 치료법이
✔ 글로벌 임상 및 학회 발표를 통해 빠르게 진전되고 있는 것입니다.

결론 — 스웨덴 췌장암 연구의 요점
- 스웨덴 기업들은 췌장암의 KRAS 돌연변이와 같은 어려운 표적을 향해 세포치료/면역치료 중심으로 임상을 확장하고 있다.
- 이런 흐름은 전통적 치료가 미약했던 췌장암 분야에 새로운 가능성을 연다는 점에서 국제적으로 주목받고 있다.
- 특히 2026년 주요 학회에서 발표될 데이터는 앞으로 치료 방향을 짚어주는 중요한 참고 포인트가 될 것이다.